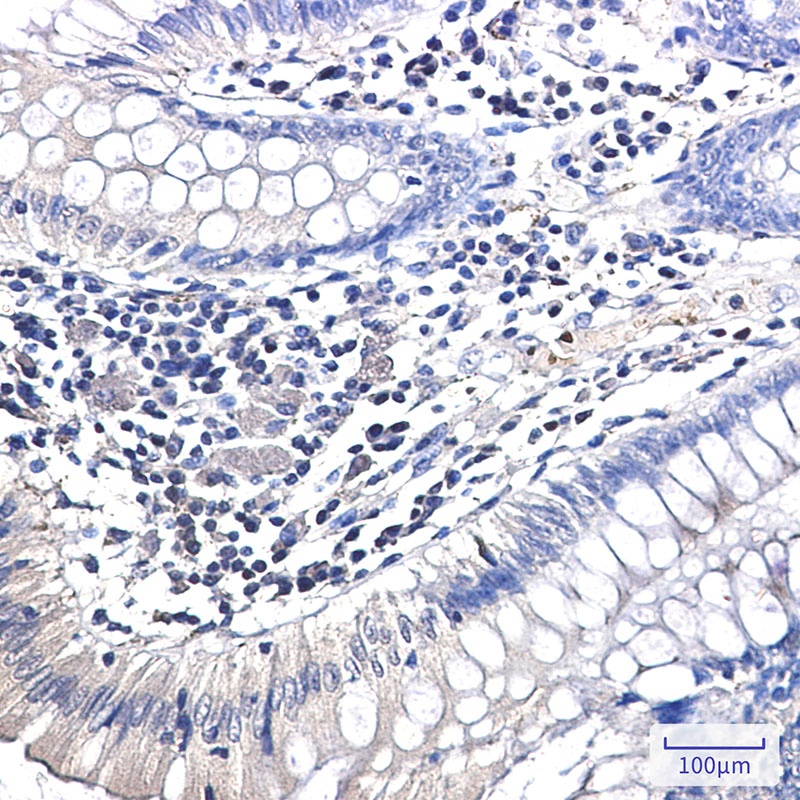
Ubiquitin K63 Rabbit mAb

You have no items in your shopping cart.
Ubiquitin K63 Rabbit mAb
Catalog Number: orb1472104
| Catalog Number | orb1472104 |
|---|---|
| Category | Antibodies |
| Description | Ubiquitin K63 Rabbit mAb Antibody |
| Clonality | Recombinant |
| Species/Host | Rabbit |
| Conjugation | Unconjugated |
| Reactivity | Human, Mouse, Rat |
| UniProt ID | P0CG47 |
| Tested applications | IF, IHC, WB |
| Antibody Type | Recombinant Antibody |
| Storage | Maintain refrigerated at 2-8°C for up to 2 weeks. For long term storage store at -20°C in small aliquots to prevent freeze-thaw cycles. |
| Note | For research use only |

Immunocytochemistry of Ubiquitin (linkage-specific K63) (green) in hela using Ubiquitin (linkage-specific K63) Rabbit mAb at dilution 1/5, and DAPI (blue).

Immunohistochemistry of Ubiquitin (linkage-specific K63) in paraffin-embedded Human colon cancer tissue using Ubiquitin (linkage-specific K63) Rabbit mAb at dilution 1/50.

Western blot detection of Ubiquitin (linkage-specific K63) in Hela, A549 cell lysates using Ubiquitin (linkage-specific K63) Rabbit mAb (1:1000 diluted). Predicted band size: 8 kDa. Observed band size: 8 kDa.
Ubiquitin K63 Rabbit mAb [orb1563584]
ICC, IF, IHC-Fr, IHC-P, WB
Human
Monoclonal
Unconjugated
100 μl, 50 μl, 20 μlK63-linkage Specific Ubiquitin Rabbit mAb [orb1951295]
FC, ICC, IHC, WB
Human, Mouse, Rat
Rabbit
Recombinant
Unconjugated
50 μl, 100 μlUbiquitin K63 Recombinant Rabbit mAb [orb2326904]
FC, IHC, WB
Human, Mouse, Rat
Rabbit
Recombinant
Unconjugated
100 μl, 50 μl, 25 μlRecombinant Ubiquitin (Linkage specific-K63) Rabbit mAb Antibody [orb2988903]
IHC, WB
Human, Mouse, Rat
Rabbit
Monoclonal
Unconjugated
30 μl, 50 μl, 100 μl, 200 μlUbiquitin K63 Rabbit mAb [orb1923724]
FC, ICC, IF, IHC-P, WB
Human, Mouse, Rat
Monoclonal
Unconjugated
50 μl, 20 μl, 100 μl
Ubiquitin K63 Rabbit mAb (orb1472104)
Participating in our Biorbyt product reviews program enables you to support fellow scientists by sharing your firsthand experience with our products.
Login to Submit a Review